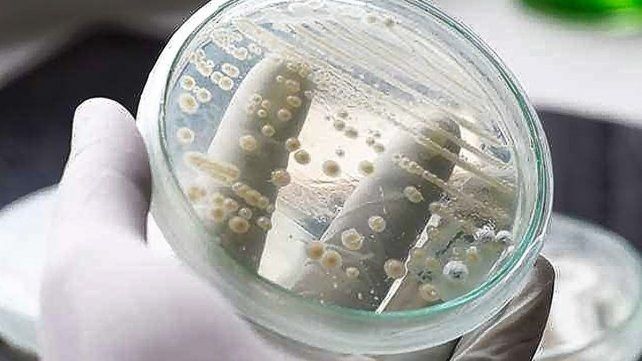
El Candida Auris es resistente a los m&aacute;s potentes medicamentos.&nbsp;

Esta semana Brasil confirmó su primer posible caso de infección por el hongo Candida auris. Se trata de un microorganismo superresistente a los principales fármacos conocidos y que es potencialmente mortal, informó el Gobierno.
Candida Auris: Brasil confirmó el primer contagio de este hongo
La Agencia Nacional de Vigilancia Sanitaria (Anvisa, regulador), vinculada al Ministerio de Salud, explicó que fue notificada el martes sobre el primer posible caso positivo del hongo, detectada en un paciente adulto que está ingresado en cuidados intensivos por complicaciones de la covid-19 en un hospital del estado de Bahía (nordeste).
Luego de conocerse el caso, Anvisa emitió una alerta a todos los servicios de salud y laboratorios de microbiología de Brasil para que puedan adoptar las "acciones de prevención y control de la diseminación de ese hongo de forma oportuna y segura". Asimismo, detalló que las autoridades sanitarias regionales y nacionales organizaron un grupo de trabajo conjunto para «acompañar el caso y prevenir la diseminación de Candida auris en Brasil".
Cuáles son los síntomas de la Candida Auris
Los especialistas firman que se trata de una amenaza para la salud a nivel global puesto que su infección supone un riesgo para la vida del paciente. Se trata de un hongo muy agresivo que afecta a diversos órganos, especialmente en pacientes con un sistema inmunológico comprometido por otras enfermedades o tratamientos, pacientes ingresados en Unidades de Cuidados Intensivos, pacientes con nutrición parenteral o portadores de vías durante mucho tiempo o pacientes con enfermedades metabólicas. Puede producir una candidemia generalizada, es decir, que su paso a la sangre puede hacer que el hongo llegue a diversos órganos, como el sistema nervioso central, los riñones, el hígado, el sistema musculoesquelético, el bazo o los ojos.
Los síntomas de esta infección son inespecíficos, pero si conllevan fiebre, escalofríos, cansancio y malestar general, y no mejora con la toma de antibióticos. La mortalidad de la infección por Candida auris es bastante elevada, del 40-70%, dado que con frecuencia se tarda en hacer el diagnóstico de laboratorio, el hongo es con frecuencia resistente a varios tratamientos y los pacientes afectados suelen tener una inmunidad alterada de base.
Tratamiento para la Candida Auris
Para la Candida auris el tratamiento puede ser complejo, dado que varias de las cepas aisladas son resistentes a dos o más familias de antifúngicos, como el fluconazol, el voriconazol, la anfotericina B y las equinocandinas. El tratamiento debe tener en cuenta el estado del paciente y la sensibilidad in vitro del hongo antes de iniciar una pauta terapéutica.
Este hongo es difícil de identificar con los métodos de laboratorio estándar y requiere de procedimientos específicos, ya que la Candida Auris puede confundirse con otras especies de organismos eucariotas y conducir a un tratamiento inadecuado, aclaran los Centros para el Control y la Prevención de Enfermedades de EE.UU. Candida auris puede ingresar al torrente sanguíneo de una persona y diseminarse por todo su organismo, causando infecciones invasivas graves con hasta un 40 % de mortalidad hospitalaria. El microorganismo ha causado brotes en entornos sanitarios de EE.UU. y se han notificado infecciones en más de 30 países.
¿Hay tratamiento para la Candida Auris?
La mejor manera de combatir este hongo es la prevención, que debe realizarse mediante estrictas medidas de higiene por parte del personal sanitario a la hora de manipular a los pacientes. Asimismo, es esencial que los pacientes infectados por Candida auris permanezcan aislados para evitar el contagio a otros pacientes. La descontaminación ambiental se realizará mediante limpieza extrema con agua y jabón y posterior uso de productos clorados de suelos y superficies, 3 veces al día. Es importante la limpieza del material, equipo y aparatos después de la utilización con el paciente colonizado o infectado.
La infección por Candida auris no supone un peligro para la salud de la gran mayoría de los seres humanos, pero sí para personas de riesgo, para los que sí conlleva un potencial riesgo vital. Las autoridades sanitarias de todos los países, coordinadas por la OMS, están trabajando para hacer frente a este nuevo reto sanitario.
Estudios en Brasil
"Ya se están llevando a cabo los análisis de los fenotipos para verificar el perfil de sensibilidad del microorganismo» y confirmar el diagnóstico, destacó Anvisa. De acuerdo con el regulador, el Candida auris es un hongo emergente que representa una "grave amenaza a la salud global" y ha sido identificado por primera vez como causante de enfermedades en seres humanos en 2009, en Japón. El patógeno puede propagarse con especial rapidez en ambientes sanitarios y entre pacientes hospitalarios.
"Existe una propensión a brotes debido a la dificultad de identificación oportuna por los métodos en laboratorios habituales y de su eliminación del ambiente contaminado", enfatizó el regulador de Brasil. La Anvisa de Brasil igualmente alertó de que las consecuencias dejadas por el hongo pueden ser potencialmente mortales, debido a que algunas cepas del Candida auris "son resistentes a todas las tres principales clases de fármacos antifúngicos". El hongo "puede causar una infección en la corriente sanguínea y otras infecciones invasoras, lo que puede ser mortal, principalmente en pacientes con comorbilidad", precisó.
Tras los "relatos de brotes de Candida auris en servicios de salud de América Latina", compilados por la Organización Pan-Americana de Salud en 2016, la Anvisa de Brasil elaboró un documento el año siguiente en el que detalló las orientaciones para la identificación, prevención y control del patógeno por parte de los laboratorios y centros de salud del país.